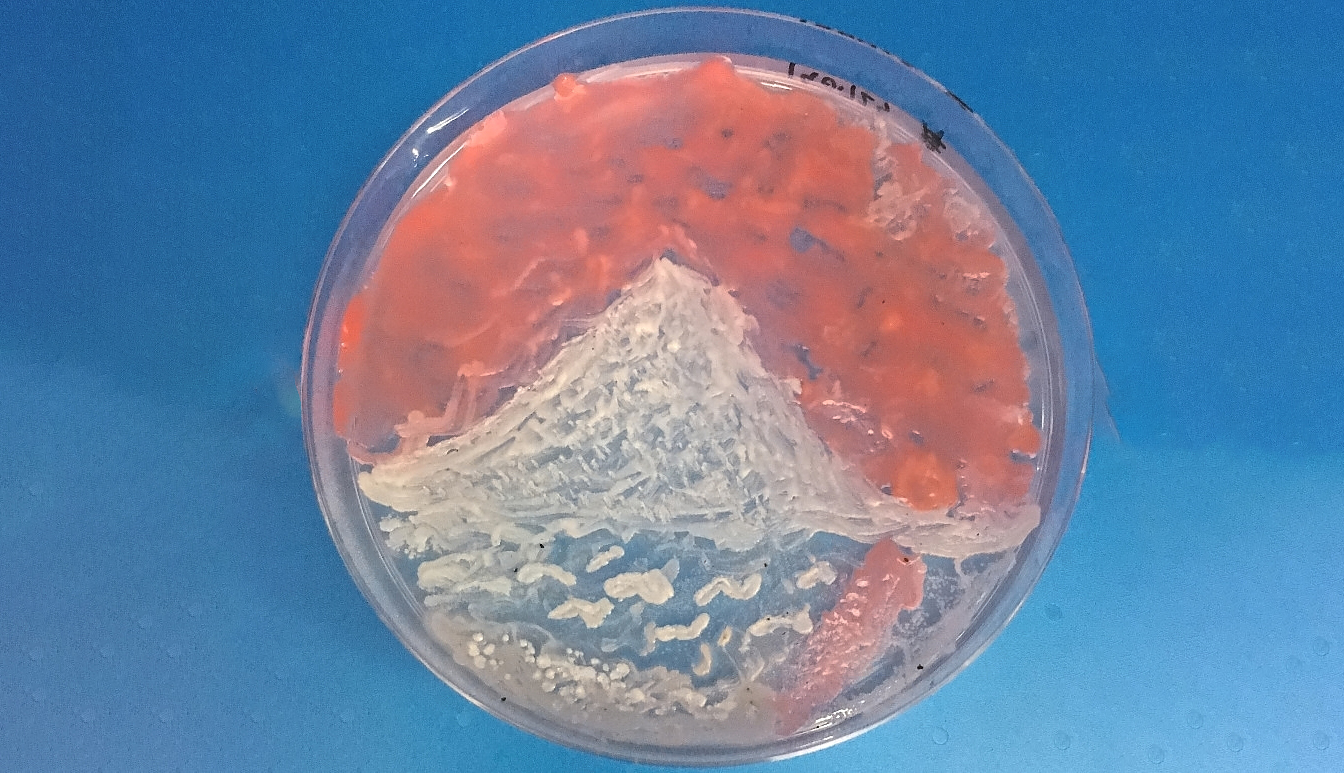
微生物で絵を描く!? 国内初の「微生物アートコンテスト」作品をご紹介

マイストア
変更
お店で受け取る
(送料無料)
配送する
納期目安:
2026.02.25 5:53頃のお届け予定です。
決済方法が、クレジット、代金引換の場合に限ります。その他の決済方法の場合はこちらをご確認ください。
※土・日・祝日の注文の場合や在庫状況によって、商品のお届けにお時間をいただく場合がございます。
【原画・一点物】微生のかたち|オリジナル抽象アート 113201-2-の詳細情報
113201-2-。constantin-brâncuşi-4.jpg。微生物で絵を描く!? 国内初の「微生物アートコンテスト」作品をご紹介。ご覧いただきありがとうございます。微細な生命体や細胞の連なりをモチーフに、形そのものと余白が持つ緊張感、そして静けさの中に潜む気配を意識して描きました。棚の上やデスク脇、壁の余白などに置くことで、空間にわずかなリズムと視線の拠り所を与えるような作品です。【作品について】・オリジナル原画(複製ではありません)・一点物・技法:手描き・モチーフ:抽象/生命体・細胞イメージ【サインについて】ご希望がございましたら、作家サインをお入れすることも可能です。【額縁について】付属の額縁は、あくまで保護・展示用の簡易的なものです。本作品はハンドメイドによる個人制作物です。ご不明な点がございましたら、お気軽にお声がけください。微生物アートの部屋 【山梨大学・田中研究室。本作は、自身で制作したオリジナルの一点物作品です。リキテンシュタイン シルクスクリーン1969年。折り紙 恋の闇 日本文化 素文。大きな絵画が空間に強い主張をもたらすのに対し、本作は周囲の環境と呼応するように、静かに存在することを意図しています。シュウ様5。よっしー 成人式のぼり旗オーダー。見る距離や角度、光の入り方によって印象が微妙に変化し、鑑賞するたびに異なる表情を感じていただけます。希一ページ。万華鏡 お問い合わせページ。ご購入後、取引メッセージにてお知らせください。折り紙 ほたる 日本文化 素文。pあーるq´ω`)♡ 様 ダイヤモンドアートオーダー。作品との関係性を考え、ご自身の感覚に合う額装へ替えていただくことを前提にお考えください。ダイヤモンドアートクラブ Foxy Lady DAC。海アート レジンアート 波アート ピンク パープル ゴールド 17cm。その特性をご理解いただける方にお迎えいただけましたら幸いです。くずきりページ。Labo diamondpainting 公式 ダイヤモンドアート キット。
ベストセラーランキングです
近くの売り場の商品
カスタマーレビュー
オススメ度 4.7点
現在、8127件のレビューが投稿されています。

.jpg)